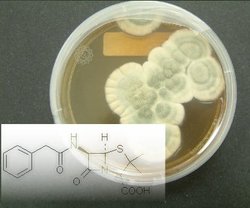

![]()
Plentisilina y penicilina: una parodia de los antibióticos y una tragedia
Traducción de un comentario de Ronald Bentley y Joan W. Bennett difundido en el foro “Considerando los pequeños detalles”
13 de marzo 2008
1946 fue un año en el que para muchos países era posible tener una esperanza de futuro. Terminaban los horrores de la Segunda Guerra Mundial y comenzaba la reconstrucción. Se reanudaron los viajes internacionales y, como se fabricaron flotas de aviones, fueron algo más fáciles que antes. Se fundaron las Naciones Unidas, una nueva organización mundial, y la Asamblea General y el Consejo de Seguridad tuvieron sus primeras reuniones en enero de aquel año. En las disciplinas científicas nuevas tecnologías, derivadas de las investigaciones bélicas sobre la liberación de energía nuclear, transformaban la investigación. Estaba en marcha el trabajo analítico que llevaría a la estructura de la doble hélice del ADN y el amplio uso de la biotecnología.
Cultivo de un Penicillium productor de penicilina y estructura de la penicilina G. Fuente: Departamento de Ciencias Farmacéuticas, Instituto de Biología Farmacéutica, de Basilea, Suiza.
En la medicina, un acontecimiento importante fue la revolución de los antibióticos que permitió controlar muchas enfermedades infecciosas hasta entonces intratables.
La penicilina, en cantidades suficientes para el uso civil estuvo disponible en los EE.UU. en 1945 y en 1946 en el Reino Unido (Bud, 2007). De hecho, la penicilina en la actualidad puede considerarse como una materia prima (Bentley y Bennett, 2008). Se creó una organización para la ayuda de países devastados por la guerra, la Administración de las Naciones Unidas de Socorro y Reconstrucción (UNRRA*), que, a partir de 1946, suministró conocimientos especializados sobre los antibióticos e incluso plantas enteras de producción de penicilina a varias naciones (Bud, 2007). Poco a poco, el uso de antibióticos se convirtió en un fenómeno a escala mundial y el término, antibiótico, entró en el vocabulario común. Un antibiótico se miraba como si fuese un fármaco milagroso que tenía un carácter más o menos general de panacea universal, que incluso se recetaba para tratar el catarro. Además, después de un programa de investigación masivo y secreto en los EE.UU. y el Reino Unido, se averiguó la estructura química de la penicilina que en 1946 pasó a ser del dominio público.
De broma a peligro
Una indicación de la amplia publicidad dada a los antibióticos fue un borrador, con una portada como la utilizada por la revista Science, distribuido en la Reunión de la AAAS (Sociedad Americana para el Avance de la Ciencia) del 27 al 30 de marzo de 1946. Este informe anunciaba el descubrimiento y la caracterización de la plentisilina- una sustancia aislada de la cáscara de plátano con la característica peculiar de no tener ninguna actividad antibiótica en absoluto. Curiosamente, contenía deuterio, 2H, además de los elementos habituales, C, H, N, O y S. Era, desde luego, una elaborada broma con el número de volumen de Science registrado como ℑ. El autor usó un seudónimo, Norman Nadir, un anagrama para Radin, que en aquel tiempo era becario en el Colegio de Médicos y Cirujanos de la Universidad de Columbia. Felizmente Radin tuvo una brillante carrera como bioquímico con muchas publicaciones serias. La parodia ha sido reimpresa (Weber, 1987).
La parodia de posguerra de Radin quería ser una broma. Pero medio siglo más tarde no es en absoluto una broma el que varios antibióticos hayan perdido, o estén en vías de perder, su eficacia. Como la plentisilina, se han convertido realmente en sustancias sin actividad antibiótica. Tras seis décadas de uso intensivo de los antibióticos se han curado muchas infecciones y salvado muchas vidas. A principios de los años 1950, algunos organismos que antes eran fácilmente controlados por los antibióticos adquirieron resistencia a esos compuestos. Las esperanzas iniciales de que el fenómeno de resistencia se pudiera controlar por el desarrollo de antibióticos nuevos, sintéticos o semisintéticos, o por la obtención de compuestos recién descubiertos, se han cumplido sólo parcialmente. Ahora, a principios del siglo XXI, la resistencia a los antibióticos es, verdaderamente, un problema serio.
Más caros y más incómodos
Un caso trágico es el tratamiento de infecciones por Neisseria gonorrhoeae, de las cuales solo en los EE.UU. ocurren aproximadamente 800.000 al año. (Wang et al., 2007). A partir de 1936, una simple gonorrea se podía controlar con sulfamidas, pero hacia 1945 un tercio de las cepas era resistente. La penicilina vino al rescate. Al principio una dosis de 50.000 unidades curaba en un solo día, pero en 1972 era necesario usar 4,8 x 106 unidades de penicilina, una cantidad mucho más grande. Como la resistencia inevitablemente se extiende, en los años 1980 tanto la penicilina como las tetraciclinas se dejaron de usar en los EE.UU como terapias para la gonorrea (Wang et al., 2007).
Las terapias sustitutorias fueron las cefalosporinas y las fluoroquinolonas. Sin embargo, las cepas resistentes a fluoroquinolonas se han extendido por todo el mundo (Tapsall, 2001) y los Centros para el Control y Prevención de Enfermedades, de EE.UU. (CDC), han financiado el Proyecto Especial de Vigilancia de las cepas gonocócicas (GISP) para vigilar las tendencias en la resistencia a fluoroquinolonas (Wang et al., 2007). No hay que decir que con el mayor uso de fluoroquinolonas la resistencia aumentó. Un hallazgo interesante fue que, después de interrumpirse los tratamientos con penicilina, la prevalencia de cepas con resistencia a penicilina ha disminuido. Al principio, los gonococos eran muy susceptibles a la administración oral de ciprofloxacina, con MIC (valores mínimos inhibitorios) de aproximadamente 0,06 mg L-1. Estos valores aumentaron, primero a 1 mg L-1 y más tarde se hicieron tan altos como 16-32 mg L-1 (Tapsall, 2001). Un reciente Informe Semanal de Morbilidad y Mortalidad (13 de abril de 2007) traía tristes noticias: el anuncio de que el CDC ya no recomienda las fluoroquinolonas para tratar las infecciones gonocócicas. Ahora el único tratamiento recomendado son las cefalosporinas. Por desgracia, estos antibióticos son caros y, a menudo, requieren ser inyectados (Wang et al., 2007).
Más mortal que el SIDA
Otro problema se refiere a una penicilina semisintética, la meticilina. Este antibiótico se parece a la penicilina G común, (benzilpenicilina) pero el grupo fenilo ha sido substituido por un grupo dimetoxifenil -, por eso el componente «met» del nombre. Fue desarrollado por la compañía Beecham; el proceso seguido desde su descubrimiento hasta su lanzamiento (1960) fue excepcional, necesitando tan sólo unos meses (Bud, 2007). Sin embargo, en un solo año, se encontró en el Queen Mary’s, un gran hospital infantil cercano a Londres, una cepa de Staphylococcus aureus resistente a meticilina. Este organismo, con las siglas MRSA (Staphylococcus aureus meticilina-resistente), se ha hecho cada vez más frecuente en los hospitales. Estas bacterias Gram-positivas han adquirido unos niveles de resistencia que convierten a una enfermedad antes fácilmente tratable en una septicemia potencialmente mortal. En los hospitales, los pacientes transplantados y los ancianos son los grupos con mayor riesgo. Además, los problemas con la MRSA han pasado a la población en general llevando a acuñar el término, MRSA adquirido en la comunidad (CA-MRSA).
Un artículo del Washington Post (17 de octubre de 2007) señala que las MRSA son ahora más mortales que el virus de SIDA; el titular dice: «El tributo del germen staph resistente a los medicamentos es más alto de lo que se pensaba«. El artículo menciona 94.000 infecciones graves y casi 19.000 muertes al año. El artículo fue inducido por la muerte de un jugador de 17 años de fútbol americano, lo que forzó el cierre en el Condado de Bedford, en Virginia, de 21 institutos para limpiarlos, esperando así prevenir otros casos. Que la víctima fuera un jugador de fútbol es interesante ya que el CA-MRSA a menudo afecta a atletas, internos de centros penitenciarios y niños.
No nos quedan antibióticos sin resistencias
Cada vez se encuentran con mayor frecuencia organismos que son resistentes a otros antibióticos potentes. De hecho la vancomicina, el supuesto «antibiótico de último recurso», es ya vulnerable. Es realmente irónico que el nombre, vancomicina, deriva de palabras relacionadas con «vencido» (p.ej., el francés, vaincre, conquistar). Las prácticas de prescripción médica dirigen la evolución de la resistencia a los medicamentos. Cuantos más antibióticos se usan mayor es la presión de selección darwiniana sobre las cepas que cada vez son más resistentes. Una descripción completa del problema de la resistencia a los antibióticos cae fuera del alcance de este ensayo. Sin embargo, dos libros recientes con títulos muy reveladores, son un tesoro de información. Son “La Venganza de los Microbios: Cómo la Resistencia Bacteriana neutraliza la Revolución de los Antibióticos” (Salyers and Whitt, 2005) y “La Penicilina: Triunfo y Tragedia” (Bud, 2007). Deberían ser de lectura obligatoria para cualquier persona interesada en el tratamiento de las enfermedades infecciosas.
LOS AUTORES
Ronald Bentley es Profesor Emérito del Departamento de Ciencias Biológicas, Universidad de Pittsburgh. Joan Bennett es Profesora en el Departamento de Biología de Plantas y Patología, Universidad de Rutgers. También es Vicepresidenta Asociada para la Promoción de Mujeres en la Ciencia, la Ingeniería y las Matemáticas, y ex Presidente de la ASM.
REFERENCIAS
Bentley, R., and Bennett, J. W. 2008. A ferment of fermentations: reflections on the production of commodity chemicals by microorganisms. Adv. Appl. Microbiol., 63, in press.
Bud, R. 2007. Penicillin: Triumph and Tragedy. Oxford University Press, Oxford.
Salyers, A. A., and Whitt, D. D. 2005. Revenge of the Microbes: How Bacterial Resistance is Undermining the Antibiotic Revolution. ASM Press, Washington, DC.
Tapsall, J. 2001. Antimicrobial resistance to Neisseria gonorrhoeae. WHO/CDS/DRS 2001.3:16. World Health Organization, Geneva.
Wang, S. A. et al. 2007. Antimicrobial resistance for Neisseria gonorrhoeae in the United States, 1988 to 2003: the spread of fluoroquinolone resistance. Ann. Int. Med. 147: 81-89.
Weber, R. L. Droll Science. 1987. Humana Press, Clifton, NJ.
* Nota de los traductores: La UNRRA fue sustituida en 1946 por la Organización Internacional de Refugiados, germen de lo que en 1950 sería la actual ACNUR.
traducción: Magaly Roldán y Miguel Vicente

Foro del día en notiweb

Otra gran entrada en este blog. Enhorabuena y gracias.
Me temo que hay una errata en el artículo sobre el tratamiento actual de las infecciones por Neisseria gonorrhoeae: No se utiliza una ciclosporina, que es un inmunosupresor como dice correctamente el enlace a Wikipedia, sino una cefalosporina de tercera generación, habitualmente la ceftriaxona.
Gracias por hacer el comentario Rafael, el error creo que ya está corregido en los foros de los dos continentes. Pido disculpas en lo que a mí concierne.
Miguel Vicente